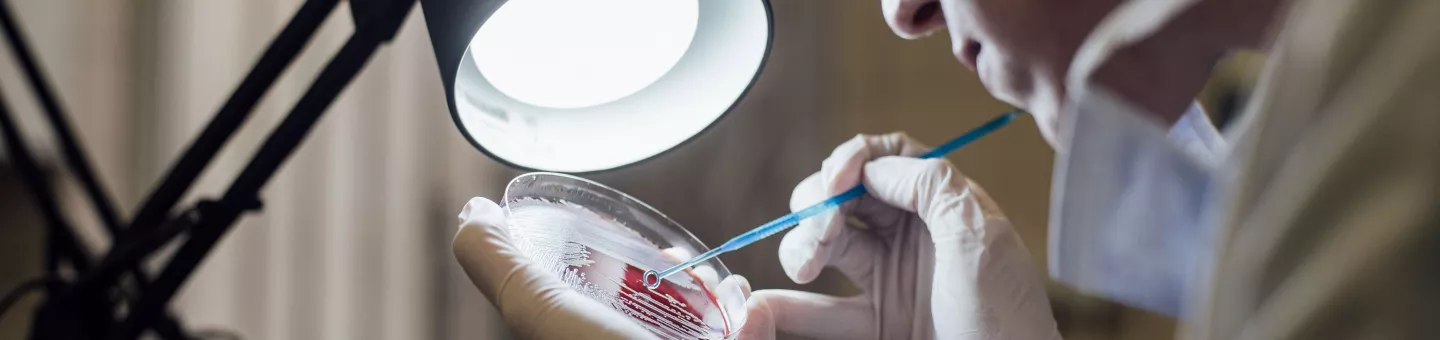
Jordanien: Labor

Berlin, 22. Juni 2023. Medienschaffende und Forschende können sich jetzt für den Memento Preis bewerben. Der Preis ist in den Kategorien Medien und Forschung mit jeweils 5.000 Euro dotiert und soll Recherchen und Forschungsergebnisse rund um das Thema “Vernachlässigte Gesundheitsbedürfnisse” fördern und ehren.
Mit dem Memento Preis wird besonderes Engagement in den Bereichen Politik, Forschung und Journalismus zu vernachlässigten Gesundheitsbedürfnissen von Menschen in von Armut betroffenen Ländern ausgezeichnet. Der Preis wird seit 2014 vom Memento-Bündnis vergeben. Teil des Bündnisses sind Brot für die Welt, BUKO Pharma-Kampagne, DAHW Deutsche Lepra- und Tuberkulosehilfe e.V. und Ärzte ohne Grenzen.
Der Memento Medienpreis
Bewerbungsfrist: 20. August 2023. Jetzt bewerben!
Mit dem Memento Medienpreis soll Medienschaffenden die Möglichkeit gegeben werden, Rechercheprojekte zu verwirklichen, die im üblichen Zeit- und Kostenrahmen nicht oder nur schwer realisiert werden können. Ziel ist es, zukunftsweisenden und kreativen Wissenschaftsjournalismus zu unterstützen, der ein breites Publikum mit fundierten Inhalten erreicht.
Gefördert wird ein Vorhaben, das über Menschen berichtet, deren Gesundheitsversorgung aus dem Fokus der Medizin, der Pharmaindustrie, der Berichterstattung oder der globalen Entscheider*innen gerückt ist: Ob Antibiotikaresistenzen oder vernachlässigte und armutsassoziierte Krankheiten, der Bedarf nach neuen effektiven Impfstoffen, Diagnostika und Medikamenten ist groß, aber die Forschung zu gering – und die Preise oft unbezahlbar. Es ist ein globales Problem, das sich besonders dramatisch in von Armut betroffenen Ländern zeigt. Dort ist außerdem in jüngerer Zeit eine rasante Zunahme an nicht-übertragbaren Erkrankungen wie Krebs oder Diabetes zu beobachten.
Der realisierte Beitrag kann in Print- oder Onlinemedien, genauso wie im Fernsehen oder Radio veröffentlicht werden. Auch journalistische Beiträge, die exklusiv für Social Media konzipiert wurden, sind willkommen.
Der Memento Forschungspreis 2023
Bewerbungsfrist: 27. August 2023. Jetzt bewerben!
Mit dem Memento Forschungspreis werden Wissenschaftler*innen ausgezeichnet, die in den letzten drei Jahren einen wichtigen Beitrag zur Erforschung und Entwicklung von vorbeugenden Maßnahmen, Diagnostika und Therapien zu vernachlässigten Gesundheitsbedürfnissen in von Armut betroffenen Ländern geleistet haben. Damit soll ihr Beitrag geehrt und die Bedeutung öffentlicher Forschung hervorgehoben werden.
Im Fokus der Forschung sollten vernachlässigte Gesundheitsbedürfnisse stehen:
- vernachlässigte Krankheiten (entsprechend der WHO-Liste)
- armutsassoziierte Erkrankungen, beispielsweise Lassa Fieber, Tuberkulose, Malaria
- vernachlässigte Aspekte von Krankheiten, zu denen umfangreicher geforscht wird, wie HIV/Aids bei Kindern oder nicht-übertragbare Erkrankungen im globalen Süden
- weitere Krankheiten, die zwar viele Menschen betreffen, für die aber keine adäquaten Präparate entwickelt werden, etwa zu antimikrobiellen Resistenzen.
Weitere Informationen
- Weitere Informationen zum Preis, der Jury und den Bewerbungskriterien finden Sie auf der Website des Memento Preises für vernachlässigte Krankheiten.
- Für Nachfragen stehen Max Klein und Corinna Krämer vom Memento-Bündnis zur Verfügung: kontakt@memento-preis.de

Vernachlässigte Krankheiten
Jährlich sterben Zehntausende Menschen an sogenannten vernachlässigten Krankheiten. Es fehlt an Diagnostika, Präventionsmitteln und Medikamenten. Wir setzen uns dafür ein, dass sich das ändert.